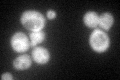
YKR014C
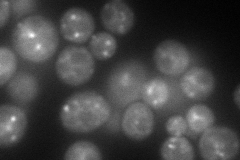
YKR014C
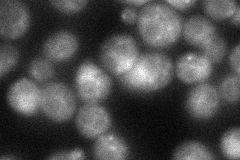
YKR014C
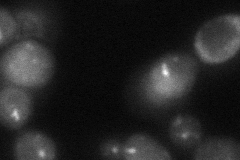
YKR014C
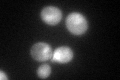
YKR014C

View description
GTPase, similar to Ypt51p and Ypt53p and to mammalian rab5; required for vacuolar protein sorting and endocytosis
Localization:
Intensity:
Fold change:
Significance:
-
C’ GFP library in SD
cytosol67.8 -
N' NOP1pr-GFP in SD
punctate,vacuole membrane106.21 -
N' TEF2pr-mCherry in SD

punctate269.3 -
N' NATIVEpr-GFP in SD
vacuole membrane48.9741 -
N' TEF2pr-VC and Cyto-VN in SD
punctate53.8312 -
C’ GFP library in SD+DTT

cytosol82.181.21No -
C’ GFP library in SD+H2O2

cytosol83.91.23No -
C’ GFP library in Starvation Media
cytosol145.112.14Yes -
C’ GFP library on the background of Pup2-DaMP

cytosol -
C’ GFP library on the background of CCT mutant

cytosol73.03881.0771No
